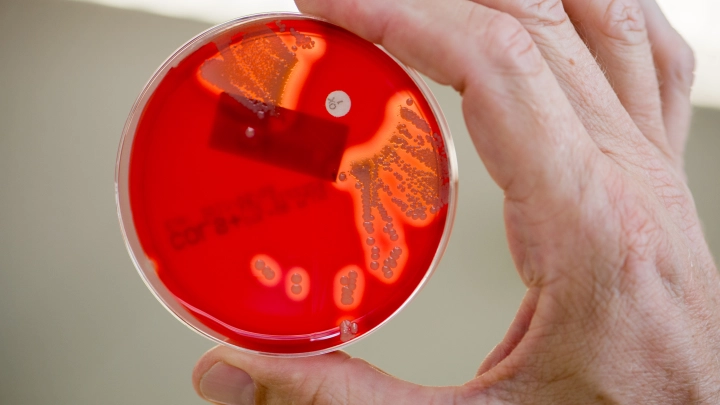
Результаты оказались шокирующими: Учёные сообщили о массовом переносчике стафилококка

"Результаты оказались шокирующими": Учёные сообщили о массовом переносчике стафилококка
Микробиологи провели исследование, результаты которого кажутся шокирующими. Повседневный предмет, который мы тащим в дом после каждой поездки, оказался рассадником опасных бактерий. Он грязнее, чем сиденье унитаза в общественном туалете.
После долгой поездки большинство из нас бросает чемодан на кровать или стул, не задумываясь. Но, как выяснили учёные, именно эта привычка может нести реальную угрозу здоровью. Результаты исследования, проведённого британской компанией InsureandGo, оказались шокирующими. Они точно заставят вас дважды подумать, прежде чем бросить чемодан на кровать дома или в гостиничном номере.
Микробиолог Эми-Мэй Пойнтер, проводившая исследование, выяснила, что ручки, колёса и днище дорожных сумок загрязнены опасными бактериями куда больше, чем сиденья унитазов в общественных туалетах.
Мазки с десяти чемоданов брали на оживлённой станции рядом с аэропортом в Лондоне. Анализ проводился в течение пяти дней - образцы хранились в питательной среде для оценки роста бактерий. И оказалось, что колёса чемоданов - настоящий лидер по бактериальной загрязнённости: 400 КОЕ (величина, показывающая количество микробных клеток. - Ред.) на три квадратных сантиметра. Это в 58 раз больше, чем на сиденьях унитазов.
На втором месте - днище, особенно у моделей с мягким корпусом, которые впитывают влагу и грязь лучше, чем жёсткие. Третьими по уровню загрязнённости стали ручки.
 Фото: Belkin Alexey/Globallookpress
Фото: Belkin Alexey/Globallookpress
Среди обнаруженных микроорганизмов - Staphylococcus aureus, способный вызывать гнойные воспаления и пищевые отравления. Также встречались кишечная палочка, указывающая на фекальное загрязнение, и бактерии рода Serratia marcesens, которые в ряде случаев провоцируют инфекции мочевыводящих путей. В некоторых пробах зафиксирован рост плесневых грибков Aspergillus и Penicillium.
По словам Пойнтер, полученные данные объясняются просто: чемоданы катаются по грязным полам, включая туалеты, улицы и платформы. Но об этом редко кто задумывается.
Рекомендуется после каждой поездки протирать колёса и дно чемодана мыльным раствором или дезинфицирующими салфетками, а после контакта с багажом обязательно мыть руки. Особенно это важно при путешествии с детьми или в осенне-зимний период, когда ослаблен иммунитет.
Любопытно, что для сравнения уровня загрязнённости учёные брали также мазки с кнопок смыва и сидений в туалетах. Результат - чемодан оказался самым грязным предметом из всех.